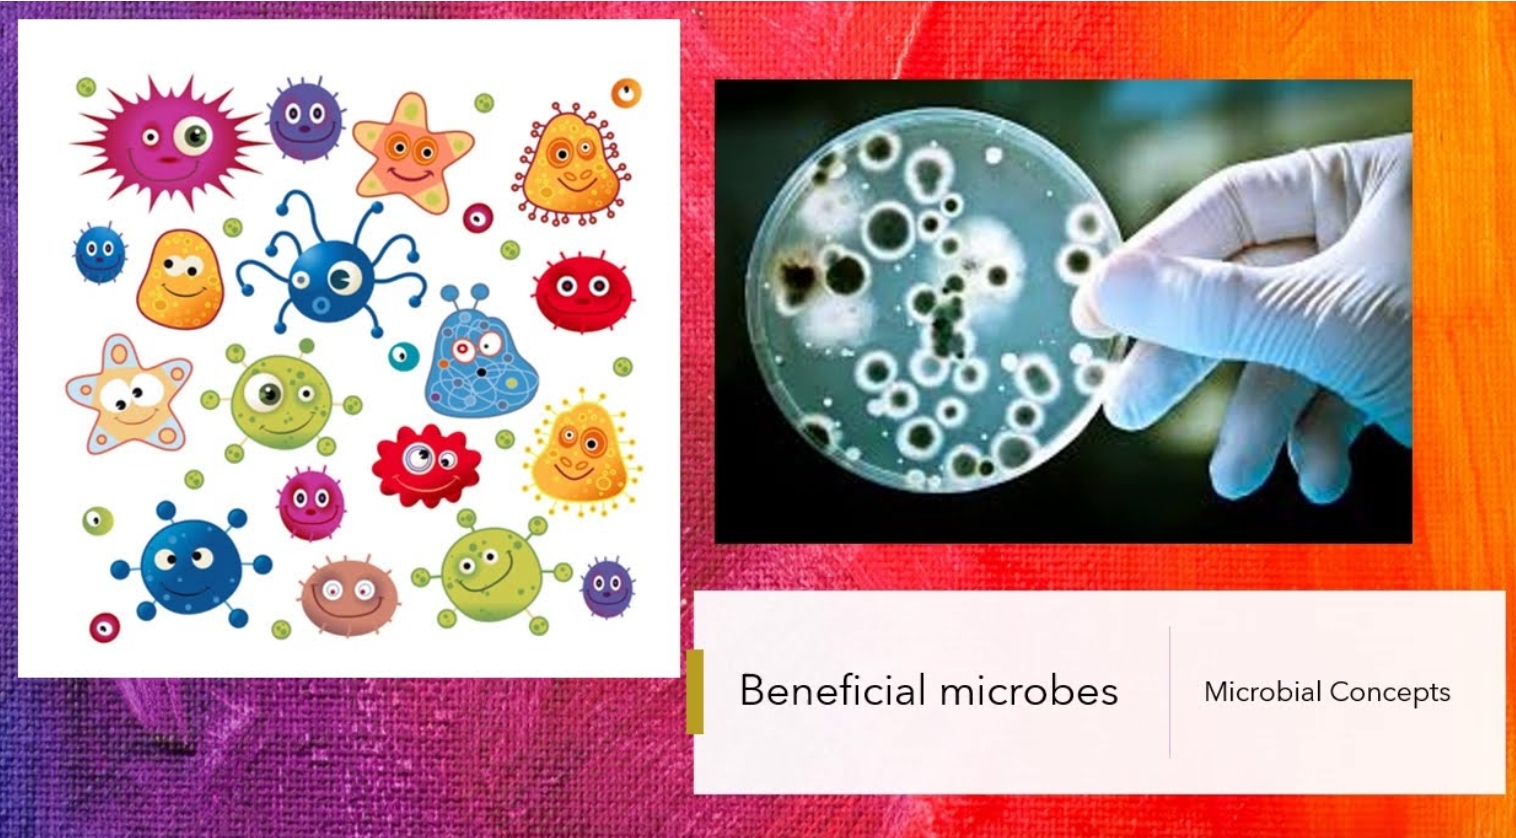

유익균 종류
인체 유익한 유익균 종류는 황국균, 납두균, 효모균, 클로렐라, 유산균 등 다양합니다.

황국균 黃麴菌 Aspergillus oryzae
단백질 , 아미노산, 무기질, 비타민 함유, 소화 촉진, 식욕 증진, 정장 작용, 신진대사 기능

클로렐라 chlorella
녹조류 단세포 생물, 비타민, 무기질 등 풍부, 체질 개선, 건강 증진 및 유지

납두균 納豆菌 Bacillus subtilis
단백질 , 아미노산, 무기질, 비타민, 소화 촉진, 식욕 증진, 정장 작용, 혈액순환 개선, 콜레스테롤 제거, 혈전 분해

효모균 酵母, yeast
단백질, 아미노산, 무기질, 비타민 B군 함유, 소화 촉진, 식욕 증진, 정장 작용, 신진대사 원활

유산균 乳酸菌 Lactobacillus
면역 조절, 감염 예방, 외부 병원균 차단
클로렐라, 납두균, 효모균, 황국균, 유산균 등 유익균 종류 45가지가 함유된 자가증식(스스로 증식)하는 복합유익균(microbiome)이 함유된 식품은 '수퍼 em원액분말' 입니다.

유익균 집합체 수퍼 em원액분말 속의 EM 미생물은 인체 건강에 이로운 작용을 하는 유익균으로, 장내 유해균 억제 면역력을 정상 수치로 조절합니다.
EM미생물은 아토피와 건선 같은 자가면역성 피부질환을 개선하며, 고혈압(연구결과) 및 대사증후군을 억제, 인슐린 저항성을 낮춥니다.

장내 EM미생물들은 장내 유익균 비율을 높여 장내 정상세균총을 복원 합니다.
장내 유익균은 뇌내신경물질에 관여해 우울증 등에도 일정 부분 도움을 준다는 연구 결과가 있습니다.
장내 유익균은 '람노오스(Rhamnose)'라는 다당류를 분비해 인체가 이에 맞서 면역반응을 유도하는 물질인 사이토카인이나 케모카인을 분비해 면역력 균형을 건강하게 유지한다는 연구도 발표되었습니다.
수퍼 em원액분말 속의 EMK8종균이 유해균을 물리치는 모습
수퍼 em원액분말 속의 유익균들은 스스로 자가증식되기 때문에 직접 배양해서 EM미생물 주스를 만들어 먹는 방법이 천기누설 105회 방송에 소개되기도 했습니다.

EM 미생물 주스 만들기
녹차, 인삼차 등 차나 물 1리터에 설탕 200g과 수퍼 em원액분말 1~2그램 넣어서 일주일 이상 발효하면 EM미생물 주스가 만들어 집니다. EM미생물 먹이로 넣어준 이당류의 설탕은 발효되어 포도당 등으로 변하고 이당류의 설탕은 없어져 0%가 됩니다.
복합유익균(microbiome)이 함유된 '수퍼 em원액분말'은 하루 한번 1그램씩 먹는 것이 좋습니다. EM미생물은 스스로 자가증식되는 유익균 집합체이기 때문에 장내에서 스스로 증식합니다.

복합유익균(microbiome) '수퍼 em원액분말'을 연구개발한 이엠생명과학연구원은 카이스트 교수와 생명공학연구원들에 의해 발족된 연구소입니다.








관련검색어
유익균 종류 1위 식품 장내 유익균 음식 식이균형식 장내 세균 유익균 복합 유익균 늘리는 방법 복합유익균 식이균형식 분말 장내 유익균증식방법 EMK8종균 이엠케이팜 (이엠팜) 이엠발포멀티유산균 이엠케이팜 (이엠팜) 복합유익균 식이균형식 정 EM 이엠 유산균 종류 최다 함유 1위
2
공감한 사람 보러가기댓글 1공유하기
클리닉
클리닉
건강·의학
Science News 지구마이크로바이옴 휴먼바이크로바이옴
이웃추가
이 블로그
휴먼마이크로바이옴
카테고리 글
B형간염 완치 간염 보균자 검사 및 백신 예방접종 만성간염 치료 방법
19분 전
0
댓글 0
유익균 종류 45가지 함유 수퍼 em원액분말
3시간 전
2
댓글 1
코로나 자가진단 키트 양성이면 약 처방 병원?
2022. 7. 26.
5
댓글 2
삼차신경통 치료 증상 원인 완치 방법?
2022. 7. 24.
2
댓글 0
전립선염 원인 증상 치료 전립선에 좋은 음식
2022. 7. 24.
2
댓글 0
이전
다음
이 블로그 인기글
코로나 7일 격리 후 전파력 오미크론 바이러스 전파기간
2022. 4. 12.
6
댓글 1
코로나 확진자 전파기간 오미크론 격리해제 후 전염 시기?
2022. 3. 24.
7
댓글 1
몸에 열 내리는 방법 열이 나는 이유 심장 열 내리는 음식?
2022. 7. 1.
3
댓글 1
배가 콕콕 쑤셔요 찌르듯이 아파요 아픈 이유 원인?
2022. 7. 17.
0
댓글 0
코로나 증상 구토 설사 복통 메스꺼움 원인 치료 방법?
2022. 4. 17.
1
댓글 1
근감소증에 좋은 음식 류신 효능?
2022. 7. 4.
3
댓글 0
대상포진 병원 어떤 과로 가나요? 대상포진 치료에 좋은 음식 1위
2022. 7. 3.
0
댓글 0
담낭 제거 수술후 좋은음식 먹지말아야할 음식
2022. 4. 2.
4
댓글 2
원인모를 멍 잘드는 병 원인 혈액암? 이유없는 멍 생기는 이유?
2022. 6. 27.
2
댓글 1
코로나 오미크론 완치후 재감염 급증 변이 바이러스 BA.5 무슨 뜻? 백신 자연면역도 뚫는다.
2022. 7. 7.
3
댓글 0
이전
다음
맨 위로
PC버전으로 보기
2
공감한 사람 보러가기댓글 1공유하기
'Microbiome' 카테고리의 다른 글
| 면역력이 떨어졌을때 증상과 자가면역에 좋은 음식? (0) | 2022.08.10 |
|---|---|
| 코로나 슈퍼 면역자 슈퍼항체 보유자 되는 법 (0) | 2022.08.09 |
| 코로나 잘 안걸리는 사람 신규확진자 급증 원인? (0) | 2022.07.24 |
| 유방암 재발 예방에 좋은 음식 나쁜음식 (0) | 2022.06.21 |
| 코로나 확진 후 면역 확진자 코로나 감염후 항체 형성 기간? (0) | 2022.06.15 |